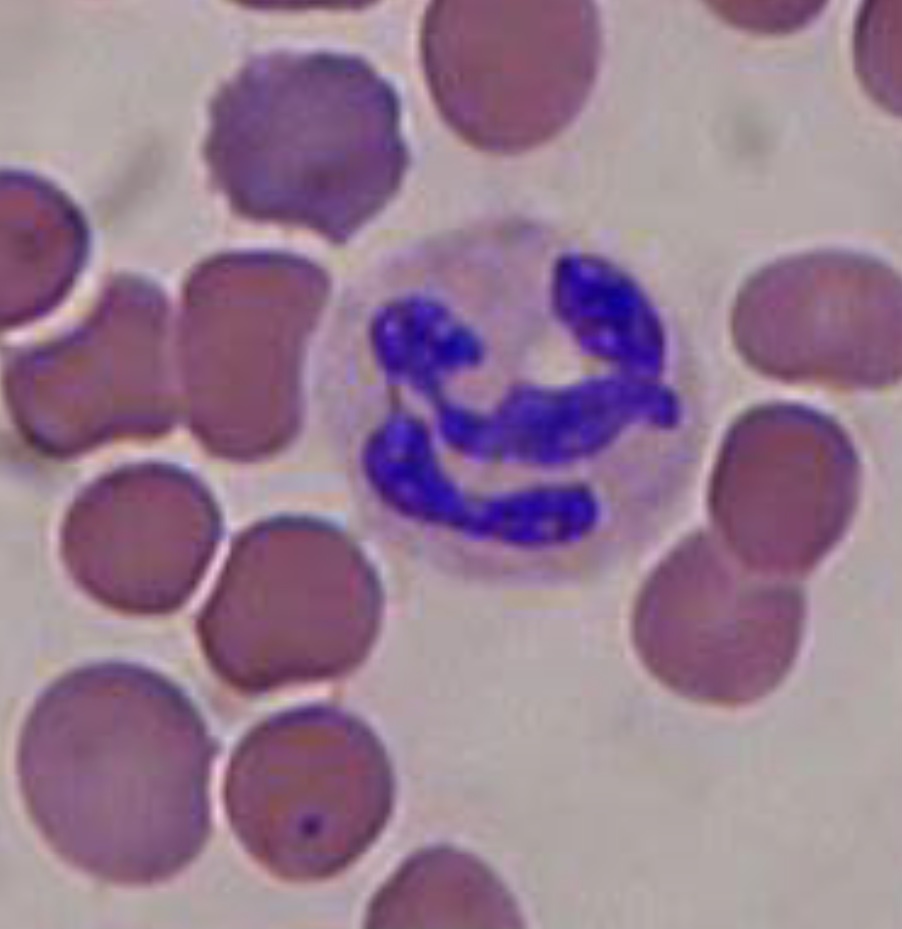
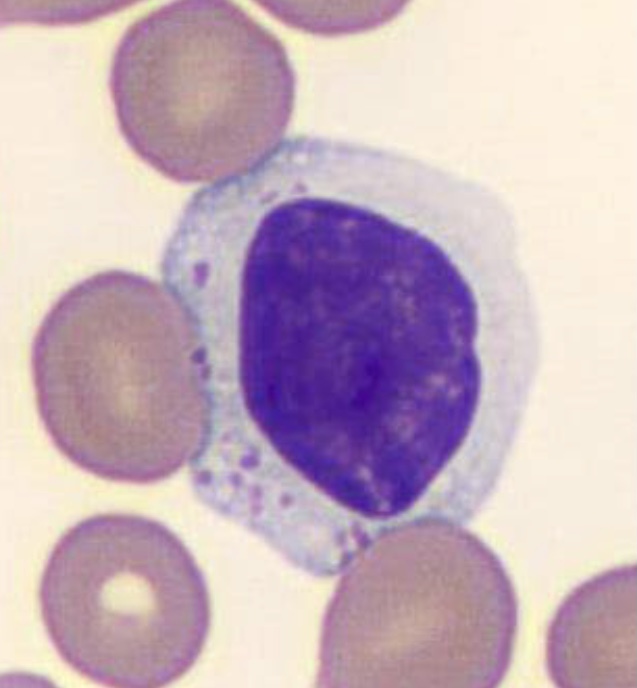

Name the type of white blood cell shown in the picture.
(It has been stained purple)
Phagocyte
Name the type of white blood cell shown in the picture.
(It has been stained purple)
Lymphocyte
What is an antigen?
Cell surface molecule which can stimulate an immune response.
Usually a glycoprotein or sometimes glycolipid or polysaccharide
Describe the process of phagocytosis
Explain the role of antigen presenting cells in producing an immune response
Phagocyte displays antigen from pathogen on cell membrane
TH cells bind to antigen and are activated
Binds to specific B and T cells and causes clonal selection/mitosis
Name the 2 types of specific immune response
Humoral
Cell mediated
Outline the process of cell mediated response
Release cytokines that stimulate
(a) Clonal expansion of complementary TH cells (rapid mitosis) become memory cells or trigger humoral response
(b) Clonal expansion of cytotoxic T cells which secrete enzyme perforin which creates holes in the target cell membrane and destroys the infected cells.
Outline the process of the humoral response
What is an antibody?
Proteins secreted by plasma cells
Quaternary structure - 2 light chains held together by disulfide bridges to 2 longer heavy chains.
Binding sites on variable region of light chains have specific tertiary structure complementary to antigen
Rest of molecule know as constant region
Name the type of specialised cell that can make the molecule shown in the diagram

Plasma cell
How do antibodies lead to the destruction of a pathogen?
Formation of antigen-antibody complex results in agglutination which enhances phagocytosis
What are monoclonal antibodies?
Antibodies produced from a single clone of B cells.
What are memory cells?
Specialised B and T cells produced from primary immune response
Remain in low levels in the blood
Can divide rapidly by mitosis if organism encounters the same pathogen again.
Contrast the primary and secondary immune response
Secondary response
Faster rate of antibody production
Shorter time lag between exposure and antibody production
Higher concentration of antibodies
Antibody level remains higher after the secondary response
Pathogen usually destroyed before any symptoms
What causes antigen variability?
Random genetic mutation changes base sequence
Different sequence of codons on mRNA
Different primary structure of antigen as H bonds, ionic and disulfide bridges form in different places in tertiary structure
Different shape of antigen
Explain how antigen variability affects the incidence of disease
Memory cells no longer complementary to antigen, individual not immune, can catch disease again
Many varieties of a pathogen - difficult to develop a vaccine containing all antigen types
Compare passive and active immunity. Give examples of both types
Both involve antibodies
Both can be artificial or natural
Passive natural - antibodies in breast milk/across placenta
Passive artificial - anti-venom, needle stick injections
Active natural - humoral response to infection
Active artificial - vaccination
Explain the principles of vaccination
Vaccine contains dead/inactive form of a pathogen/antigen
Triggers primary immune response
Memory cells are produced and remain in the blood so secondary response is rapid and produces higher concentration of antibodies
Pathogen is destroyed before it causes symptoms
What is herd immunity?
Vaccinating large proportion of population reduces available carriers of the pathogen
Protects individuals who have not been vaccinated
Suggest some ethical issues surrounding the use of vaccines
Production may involve use of animals
Potential dangerous side effects
Clinical tests may be fatal
Is it acceptable to trail new vaccines in developing countries
Can individuals be forced to get vaccinated int he interest of public health?
Should expensive vaccines be developed for rare diseases
Describe the structure of HIV
Genetic material (2xRNA) & viral reverse transcriptase
surrounded by capsid
Surrounded by viral envelope derived from host cell membrane
(GP120) attachment proteins on surface
How does HIV result in the symptoms of AIDS?
Attachment proteins bind to complementary (CD4) receptor on TH cells.
HIV particles replicate inside Tcells killed or damaging the,
AIDS develops when there are too few T cells for the immune system to function
Individuals cannot destroy other pathogens & suffer from secondary diseases/infections
Why are antibiotics ineffective against viruses?
Antibiotics interfere with the production of murein/peptidoglycan cell wall - viruses have no cell wall
Antibiotics interfere with protein synthesis- viruses use host cell organelles to make proteins.
Viruses replicate indie host cells - difficult to destroy them without damaging normal body cells.
Suggest 2 clinical uses of monoclonal antibodies
Pregnancy tests by detecting HCG hormones in urine
Diagnostic procedures eg ELISA test
Targeted treatment by attaching drug to antibody which delivers drug to cells with abnormal antigen